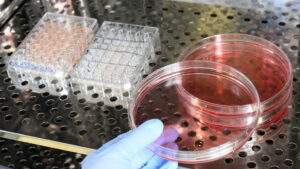

Adele confesó haber estado al borde del alcoholismo: “Lo echo de menos”
La cantante y compositora Adele ha decidido mostrarse lo más humana y cercana posible ante sus seguidores en su último concierto de

La cantante y compositora Adele ha decidido mostrarse lo más humana y cercana posible ante sus seguidores en su último concierto de

En las últimas horas Maluma confirmó en un concierto que dio en Washington la noticia de que será padre de una nena

La selección argentina de futbol ha quedado envuelta en un escándalo luego de que se descubriera que el jugador Alejandro

A fin de seguir supliendo las necesidades diarias de la población nicaragüenses en pro de mejorar su calidad de vida,

Una docena de brigadistas comprometidos en la lucha contra enfermedades transmitidas por mosquitos, tales como el dengue, chikungunya y zika,

El ministro de Hacienda y Crédito Público, Iván Acosta, resaltó la importancia que representa hoy para Nicaragua la firma en

Nicaragua y Rusia firmaron en Moscú un memorando de entendimiento en temas de derechos humanos con el propósito de fortalecer

Los candidatos a la Presidencia de Argentina cerraron sus campañas electorales de cara a los comicios pautados para el próximo

El aumento de la presencia militar extranjera en el área del conflicto palestino-israelí lleva inevitablemente a una escalada, y la

La Casa Blanca admitió este jueves que reveló accidentalmente en sus redes sociales las identidades de varios de sus comandos

Un hombre que amenazó con matar a su novia, a la que había conocido en una aplicación de citas, fue
Un equipo internacional de investigadores codirigido por Peter Fineran, de la Universidad de Otago (Nueva Zelanda), y el Dr. Rafael